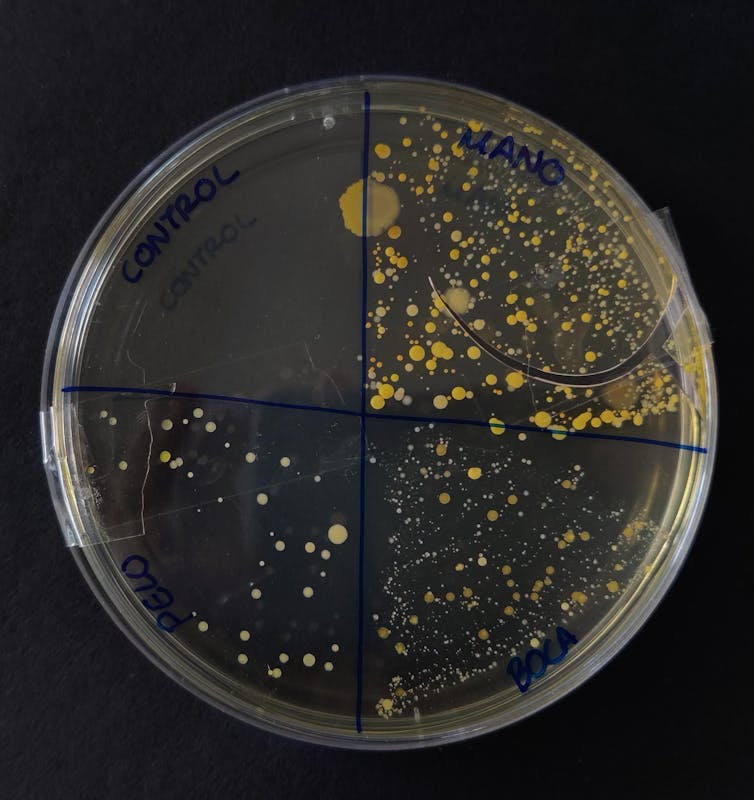

Actualmente, temáticas como la microbiota están teniendo una gran repercusión mediática, utilizándose indistintamente, de forma frecuente, los términos “microbiota” y “microbioma”. El término microbiota hace referencia al conjunto de microorganismos (bacterias, arqueas, protozoos, levaduras, hongos y virus) que conviven con nosotros de forma natural. El microbioma podría definirse como una compleja red de interacciones que establecen estos microorganismos con nuestras células. ¡Sería algo así como un ecosistema microscópico!
La enseñanza de la microbiota se lleva a cabo en las aulas de ciencias de secundaria al trabajar contenidos de microbiología. Pero comprender la microbiota y sus funciones de forma global requiere aplicar la visión Una sola salud.
Esta visión parte de la premisa de que la salud animal, la salud ambiental y la salud humana son interdependientes. De este modo, nuestra salud dependerá de más factores que tener un estilo de vida activo y una dieta saludable. La salud animal y la de nuestro planeta desempeñan también un papel muy importante. En definitiva, se trata de plantear el concepto de microbiota desde una perspectiva global, porque todo está conectado.
Enseñar la microbiota desde la visión ‘Una sola salud’
Somos superorganismos formados por millones de microbios procedentes del exterior. Comprender nuestro organismo de forma íntegra implica desarrollar una visión sistémica. Esto requiere plantear actividades que ayuden a comprender la influencia de factores de las tres esferas de Una sola salud (salud animal, ambiental y humana), relacionándolas con la noción de microbiota. Para ello podemos presentar diferentes escenarios de la vida real en los que figure el contacto humano con los animales y el ambiente.
Proponemos cuatro pasos a seguir para crear situaciones de aprendizaje sobre la microbiota con este enfoque de Un solo microbioma:
1. Experimentar para comprobar que existen microorganismos en distintas partes del cuerpo.
A pesar de que la mayor diversidad microbiana se encuentra en el intestino grueso y en la boca, nuestros microbios colonizan muchas más partes del cuerpo como la piel, la vagina, el tracto respiratorio e incluso el útero. Su diversidad dependerá, en gran medida, de nuestra relación con el ambiente y su microbiota.
Comprobar experimentalmente esta simbiosis entre nuestro organismo y los microbios, así como su distribución, es muy sencillo. Solo necesitaremos unas placas de cultivo, unos hisopos y un voluntario o voluntaria para sembrar sus “pequeños inquilinos”. Esto nos permitirá comprender, además, que aunque cada parte del cuerpo tenga su propia microbiota, su influencia en nuestro organismo es sistémica, ya que le afecta en su conjunto.
Los autores, CC BY-SA
2. Mapear microorganismos en el cuerpo.
Elaborar estos mapas después de realizar el experimento ayuda a que el alumnado identifique en qué partes del cuerpo hay microorganismos, además de las que ya cultivaron. Usando un código de colores pueden diferenciar microorganismos beneficiosos frente a perjudiciales.
En nuestro cuerpo existen más de 10 000 especies de microbios. De todas ellas, menos del 1 % se pueden considerar potenciales patógenos. Estos no supondrán un peligro para nosotros siempre y cuando se mantengan en equilibrio.
Una alteración en nuestros microbios se conoce como disbiosis. Esta disbiosis puede aparecer por varios motivos, como el consumo de antibióticos, el estrés e incluso los cambios en el clima o los contaminantes. De este modo, prevenir cambios nocivos en nuestra microbiota significa también cuidar de nuestro planeta.

Los autores, CC BY-SA
3. Identificar factores de las tres esferas de la salud y conectarlos entre sí para entender la noción Un solo microbioma.
Hasta ahora, el alumnado ha podido trabajar aspectos relacionados con la distribución y abundancia de sus microorganismos. En este nuevo paso, pretendemos analizar cómo cada una de las tres esferas (humana, animal y ambiental) influyen directamente en nuestra microbiota: las características de cualquier ser vivo están condicionadas por el ambiente en el que se desarrolla, y los cambios ambientales que influyeron en nuestra evolución también afectaron a nuestros microbios.
4. Modelar para poner en práctica el pensamiento científico y sistémico.
Para practicar el pensamiento sistémico proponemos elaborar un modelo en el que se relacionen las tres esferas de Una sola salud en un hipotético caso real de una persona con un estilo de vida y un perfil de microbiota determinados.
Este sería nuestro modelo Un solo microbioma, que podemos ofrecer a los estudiantes ya preparado para que lo relacionen con sus casos prácticos individuales o incluso podemos pedirles que lo elaboren ellos con una serie de datos que les proporcionemos.

Los autores, CC BY-SA
Una visión global de la salud y los microorganismos
Visualizar microorganismos mediante la experimentación y elaborar mapas con su distribución y modelos para entender las interacciones puede ayudar a desarrollar una visión global sobre cómo las tres esferas del concepto Una sola salud influyen en nuestra microbiota.
Sin embargo, los currícula de ciencias continúan presentando los contenidos de forma compartimentada, pues la salud y el medio ambiente se estudian como bloques independientes. Además, la microbiota tiende a estudiarse exclusivamente desde la salud humana.
Integrar los contenidos de medio ambiente y salud es fundamental para desarrollar una visión global de la microbiota.
Las situaciones de aprendizaje que planteemos a nuestro alumnado han de procurar integrar, en lugar de diferenciar, las tres esferas de Una sola salud.
Para avanzar hacia un modelo de enseñanza del tipo Una sola salud hace falta la educación científica de la sociedad y un diálogo continuo entre educadores/as e investigadores/as.
Irene González Costa, Investigadora predoctoral FPI en el grupo RODA, Universidade de Santiago de Compostela; Blanca Puig, Profesora Titular de Universidad. Didáctica de las Ciencias Experimentales, Universidade de Santiago de Compostela; Ignacio López-Goñi, MIembro de la SEM (Sociedad Española de Microbiología) y Catedrático de Microbiología, Universidad de Navarra y Paloma Blanco Anaya, Profesora Titular de Universidad, Universidade de Santiago de Compostela
Este artículo fue publicado originalmente en The Conversation. Lea el original.
¿Qué es DUPAO magazine? Somos la revista de Culturizando sobre Series y Películas, Ciencia y Tecnología, Marketing y Negocios, Productividad, Estilo de Vida y Tendencias.